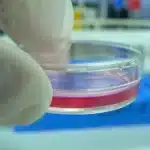
Researchers Secure .8M to Bioprint Personalized Kidney Tissues

[ad_1]
Evaluate Prime 7 Slippers
Extra Slippers We Love
{Photograph}: Boutayna Chokrane
Bearaby Pillow Boots for $149: These indoor booties are, in reality, created from Bearaby pillows and wrapped in natural cotton. They’re uber-snug, cozy sufficient to put on with out socks, and surprisingly do not make your ft sweat as most slipper boots do. They’re breathable and machine-washable, however they must be hung dry, which might take fairly a while. Sizing can be restricted to small, medium, and huge, with the most important becoming as much as a males’s 10.5 or a ladies’s 12.5. The soles aren’t designed for out of doors use, however Bearaby claims they’re snug sufficient to sleep in. (I personally is not going to be doing that.)
Verloop Slide Slippers for $44: Verloop has a few of the most colourful designs I’ve examined. Sadly, they’re flimsy and do not supply a lot assist, particularly when you’ve got plantar fasciitis. Fleece-lined and manufactured from hypoallergenic yarn, they really feel gentle, however they will not maintain your ft heat in chilly temperatures. I do recognize that they are machine-washable. Verloop additionally sells Home Socks, that are a minimum of hotter than its Slide Slippers.
Glerups Slip-On with Leather-based Sole for $100: These slip-on wool slippers with a calfskin sole match extra like a sock than a lot of the slippers I personal, which can be why I’ve discovered myself going to them increasingly over the previous yr. The physique of the slipper is a half-inch of tight-knit wool that feels nearly like crafting felt and is heat within the winter with out being sizzling in the summertime. The wool used is a mix of Danish Gotland sheep and a breed from New Zealand, and I’ve by no means felt a tingle of an itch. Wool is of course odor-resistant, which is nice for slippers, and my pair of Glerups nonetheless smells about as contemporary because the day I received them. —Martin Cizmar
{Photograph}: Martin Cizmar
Cozy Earth Lakehouse Clog for $128: The cork styling channels the long-lasting Birkenstock clog, however in contrast to Birks, the suede leather-based footbed is gentle sufficient to slowly mould underfoot. The felt high is gentle however not particularly heat. They appear nice and could be worn out to the shop if you happen to do not need to decide to them as home sneakers. —Martin Cizmar
Cozy Earth Puffy Sheep Slippers for $98: I am so jealous of my 9-year-old daughter, who has been testing these ultra-luxe slippers for me, since they’re not accessible in my measurement. They put puffy within the title, and certainly, they really feel extra like cotton balls than sneakers. In case you’re in search of spa-ready slippers, these are simply the ticket. They do have a sturdy rubber sole, nonetheless, so whereas your ft are encased in ultra-soft sheep fur and shearling, you may run out to the mailbox after which wipe the only off. —Martin Cizmar
Lūvons Francesca Black Velvet Idler Slippers for $110: These closed-back loafers are attractive, designed with a velvet higher and cushioned with fake shearling lining. The OrthoLite reminiscence foam footbed and built-in arch assist are particularly invaluable for these with plantar fasciitis. They’re crafted with anti-slip rubber soles, to allow them to be worn indoors and open air; plus, they’re machine cleanable and include a mesh laundry bag to take action. Sadly, they are not essentially the most snug (partly due to the inflexible toe field) regardless of the elastic aspect panels that should stretch together with your ft. So, these will not be my all-day, on a regular basis slippers, however on an evening after I’m internet hosting, I am pulling these out.
Haflinger GZ Basic Grizzly for $155: After I moved to Portland, Oregon, my mother’s Christmas current to me that first yr was a pair of those slippers. That was greater than 15 years in the past, and I absolutely count on these to final one other 10. I’m sporting them proper now, they usually’re in nice situation—significantly better than my husband’s L.L. Bean slippers, which kicked the bucket after about 5 years (sorry, Julian!). This slipper has an unfair benefit as a result of it’s far more of a clog, with a wool felt higher firmly connected to a light-weight, molded cork sole that’s additionally wool-lined.
I extremely suggest these when you’ve got plantar fasciitis or different foot issues that make it onerous or painful so that you can stroll with out assist. The higher has retained its form, and the cheery embroidered border has not come undone, regardless of years of being kicked into my shoe rack and left to molder all summer time. The traction on the underside can be ok for me to skitter outdoors to take out the rubbish. I put on them with socks and haven’t seen any odor. —Adrienne So
Courtesy of Rothy’s
Rothy’s Males Slipper for $79: Made with a mixture of three plastic bottles and Accountable Wool Customary-certified merino wool, Rothy’s slippers are delightfully heat whereas providing sufficient traction within the gum outsole to Get Stuff Achieved™. They’re a comfortable match, and I just like the fluffy sherpa lining to guard the again of my heel. I wouldn’t put on these outdoors, however if you happen to do by accident step out as a result of they simply really feel so dang good (as I’ve), you may toss them within the wash to wash them (simply allow them to air dry). —Julian Chokkattu
Manitobah Fake Fur Avenue Moccasins for $100: As a child, I used to be seldom and not using a pair of moccasins. My grandma received them for all of the grandkids yearly at Christmas, and I wore them all over the place. The gentle, snug indoor-outdoor shoe was simply an on a regular basis a part of life. As I received to center college, I gave in to social strain and my want to be as incognito as potential, and step by step moved away from sporting or doing something visibly Indigenous, something visibly Mexican.
After my grandma’s demise, I got down to discover a new pair of moccasins related in type to those she received us as children, and I stumbled upon Manitobah. That is an Indigenous-owned model staffed with Indigenous designers, and its slippers, cabin clogs, boots, and moccasins are all of impeccable high quality. The road moccasins are like little clouds you may slip your ft into and put on wherever, embellished with beaded designs identical to those my grandma used to get us. Manitobah additionally has a small market web page with distinctive designs. —Jaina Rodriguez Gray
Incessantly Requested Questions
Find out how to Select the Excellent Slippers
Comfortable or supportive? Would you like slippers which can be extra like a sock or extra like a correct shoe with an insole, arch assist, and a well-defined footbed? Our group likes each, however every reviewer appears to favor one type or the opposite.
Indoor solely? Do you propose to make use of your slippers solely inside your house or to make occasional journeys outdoors to choose up a package deal or toss a can within the recycling bin? Whereas we’re agency believers in holding the soles of your home slippers clear, a sturdy sole offers you extra choices. Then again, it is much less snug. In case you get high-quality slippers with a correct sole, you can additionally plan to ultimately demote them to the mudroom for fast jaunts outdoors.
Grippy or slippy? Do you need to slide round your flooring or have a backside with some gripping energy? Some individuals actually like to slide round after sliding into their slippers.
How heat? It will differ drastically by local weather, however if you wish to maintain your toes toasty, go for wool (shearling linings with the leather-based connected are the warmest), and if you happen to’re simply seeking to maintain the draft out, go for cotton or polyester.
What Are We Testing Subsequent?
[ad_2]







-Offwhite-Background-SOURCE-Rothy's.jpg)